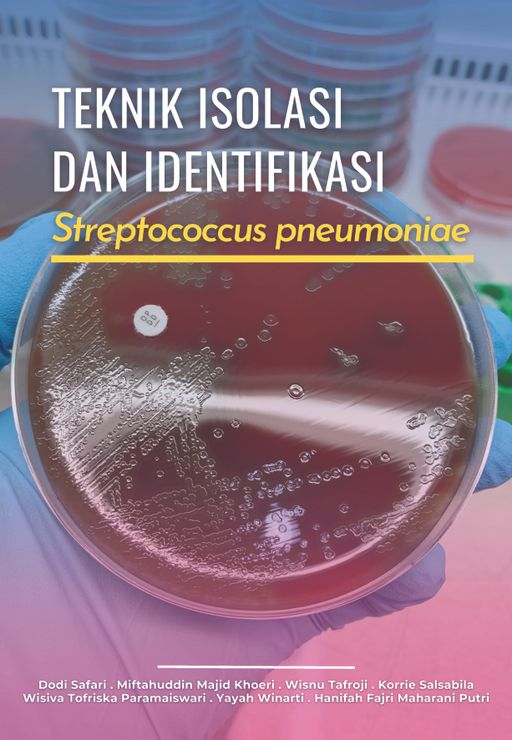
Teknik Isolasi dan Identifikasi Streptococcus Penumoniae

1001 Mitos Madu
Rp135.000
Mengenal DNA & Kromosom
Rp142.000
Etnosains Interaktif : Konsep IPA SD Berbasis Etnopedagogi Berbantuan AR
Rp7.000
BASIS DATA ORACLE 11G
Rp70.000
Teknologi Biomaterial Maju Bagian 1: Prinsip, Klasifkasi, Dan Aplikasinya Dalam Sistem Pengantaran Obat Dan Pupuk
Rp80.000
MASTERING GAS, LNG & PIPELINES : COMMERCIAL AND LEGAL INSIGHTS
Rp170.000
INNOVATION AND CREATIVITY : NATURAL HISTORY OF INNOVATION
Rp80.000
PANDUAN PRAKTIS UNTUK TEKNISI
Rp109.000
MANAJEMEN MARKETING DI ERA AI DAN ROBOTIK
Rp70.000
Transformasi Administrasi Publik Melalui Digitalisasi Dan Kecerdasan Buatan
Rp76.000
Sains Dan Sosial : Harmoni Pengetahuan Dalam Kehidupan Manusia
Rp70.000
PANDUAN PRAKTIS DEKONTAMINASI PESAWAT TERBANG YANG TERKONTAMINASI ZAT RADIOAKTIF
Rp113.000
PERADABAN BARU DENGAN ARTIFICIAL INTELLIGENCE
Rp70.000
Peran Herbal Medik dalam Bidang Kedokteran Indonesia
Rp193.000
CLINICAL ENGINEERING AND ITS ESSENTIAL ROLES IN THE HEALTHCARE SYSTEM
Rp90.000
Eksplorasi dan Penelitian Mikroalga Indigenous Indonesia
Rp106.500
Dispersi dan Konvergensi Sains: Peran Sosiologi di Era Nanopartikel Teknologi
Rp100.000
Diagnosis dan Tata Laksana Kerontokan dan Kebotakan Rambut
Rp96.400
Implikasi Biopsikososial Maloklusi dan Kaitannya dengan Kebutuhan Perawatan Ortodonti di Masa Mendatang
Gratis
Pengembangan Nanovesikel untuk Formulasi Sediaan Herbal dalam Menunjang Industri Farmasi dan Kosmetik di Indonesia
Gratis
Potensi Lignoselulosa Dalam Mendukung Kemandirian Bangsa Dalam Penyediaan Bahan Baku Farmasi Khususnya Eksipien Turunan Selulosa
Gratis
Pengantar, Konsep Dasar, dan Aplikasi: Biorisiko dan Keselamatan Hayati Laboratorium
Rp51.000
Perencanaan Kontinjensi bagi Pekerja Migran Indonesia di Sektor Minyak dan Gas Bumi (Migas) Di Aljazair dan Irak
Rp78.000
Buku Panduan Penangan Spesimen untuk Pemeriksaan Mikrobiologi edisi 2
Rp68.000
Sistematika Tumbuhan
Rp225.000
Teknik Isolasi dan Identifikasi Streptococcus Penumoniae
Rp120.000
Protokol Prediksi Sedimentasi Waduk
Rp4.920
Pedoman Pelaksanaan Pencitraan Payudara : Mammografi
Rp7.440
Pengendalian Proses; Batch dan Kontinyu
Rp9.780
KISAH ANGKA DAN KEHIDUPAN
Rp100.000
STRUKTUR BETON 2
Rp15.000
STRUKTUR BETON 1
Rp15.000
PERILAKU RETAK PELAT BETON PANEL PRACETAK KOMPOSIT PADA DECK SLAB JEMBATAN JALAN RAYA
Rp15.000
KINERJA BETON: SELF COMPACTING CONCRETE (SCC) (ANALISA MENGGUNAKAN KERIKIL PUTIH)
Rp10.000
KELAYAKAN PENGEMBANGAN PELABUHAN PENGUMPAN REGIONAL
Rp87.500
Prediksi Lintasan dan Laju Pusaran Siklon Tropis
Rp5.000
Metode gravitasi : aplikasi identifikasi awal zona subduksi
Rp15.000
Sistem peringatan dini banjir berbasis IOT
Rp20.000
QUALITY & INNOVATION IMPROVEMENT: implementasi Pada Bisnis dan Industri Modern
Rp24.000
QUALITY & INNOVATION IMPROVEMENT Implementasi Pada Industri Beton Precast (Petunjuk Praktis)
Rp75.000
Interferometri seismik
Rp20.000
The great invader : Covid-19
Rp8.500
Dasar-dasar Akuisisi Data MASW dan MIkrotremor
Rp7.000
Komunikasi Keperawatan
Rp5.700
Kerangka Acuan Standar Kompetensi Geografi Nasional
Rp40.000
Memahami Penginderaan Jauh Mandiri
Rp140.000
Metode Penelitian untuk Semua Generasi
Rp75.000
Radiologi Forensik Cedera Kepala
Rp17.000
Logika Fuzzy untuk Model Penunjang Keputusan
Rp15.000
Sistem Penunjang Keputusan
Rp4.000
Publikasi dalam Jurnal Medis : Sudut Pandang Editor Edisi 1
Rp75.000
Pediatric Neuropharmacology The Prescriber's Guides 2020
Rp84.600
Membangun Pertanian Sembalun Melalui Pemanfaatan Pupuk Organik
Rp26.300
Rekayasa Inovasi dan Nilai Tambah pada Pembangunan Mega Proyek Infrastruktur : Prasti Tunnel
Rp128.800
Teknologi dan Aplikasi : Elektrolisis Plasma
Rp117.600
Hambatan Kapal Multihull
Rp71.100
Berpikir Desain : Pendekatan Sistematis untuk Kultivasi Inovasi dalam Organisasi
Rp55.400
Aliran Fluida Non-Newtonian
Rp75.600
Risiko dan Pencegahan Kanker : Ditinjau dari Sisi Genomik dan Non-Genomik
Rp15.500
Penanganan Covid 19 : Pengalaman RSUI
Rp6.500
Diare dan Penyakit pada Sistem Pencernaan
Rp7.000
Aljabar Linear Dasar : Penelitian, Strategi Pembelajaran, dan Pokok Bahasan
Rp10.000
Proses Penelitian Kuantitatif
Rp2.800
Healthy Nurse : Napping Sehat Bagi Perawat dan Tenaga Kesehatan
Rp4.500
Potensi Terapi Sel Punca Untuk Sirosis Hati
Rp4.500
UI Peduli Kajian Terapi Sel Punca Untuk Anak Berkebutuhan Khusus
Rp4.400
Pedoman Diagnosis dan Tatalaksana Melasma di Indonesia
Rp1.200
Buku Panduan Penanganan Spesimen Untuk Pemeriksaan Mikrobiologi
Rp2.500
Proses Verifikasi Piranti Lunak Basis Data dengan Lingu dan Theorem Prover Hol
Rp3.360
Virus : Mikroorganisme Terkecil yang Menyebabkan Penyakit
Rp7.200
Pemanasan Global dan Perubahan Iklim
Rp4.500
Asam, Basa, dan Garam
Rp4.000
Sekolah Yes! Nikah Muda No!
Gratis
Ancaman Kencing Tikus
Gratis
Konservasi Alam Dalam Islam
Rp13.000
265++ Pertanyaan Sains Paling Seru & Norak
Rp6.500
Benar-Benar Unik, tapi Nyata: 1100++ Fakta Unik dan Menakjubkan
Rp6.600
301++ Hewan & Tumbuhan Mengagumkan di Dunia
Rp6.500
Worst 10: Fakta Terburuk & Menyeramkan di Dunia & Indonesia
Rp6.890
Terbukti Pome Tumpas Penyakit
Rp2.800
Super Brain : Aktivasi Otak Tengah
Rp3.900
Dahsyatnya Sirsak Tumpas Penyakit
Rp2.500
Kartu Ajaib Rumus Kimia SMP
Rp2.500
Kartu Ajaib Rumus Kimia SMA
Rp3.500
Kartu Ajaib Rumus Fisika SMP
Rp3.500
AMAZING TOP 10 : 510++ FAKTA PALING LUAR BIASA DI DUNIA
Rp6.900
KARTU AJAIB RUMUS FISIKA SMA
Rp3.650
JAWARA FISIKA SMA
Rp3.500
EASY LEARNING KIMIA SMA
Rp3.950
BUKU PINTAR RUBIK
Rp2.890
MENJADI JUARA OLIMPIADE FISIKA SMA
Rp2.650
BEBAS PENYAKIT GINJAL & SALURAN KEMIH
Rp4.300
ATLAS BERGAMBAR DINOSAURUS
Rp3.950
TUMPAS HEPATITIS DENGAN RAMUAN HERBAL
Rp4.200
RAMUAN LENGKAP HERBAL TAKLUKAN PENYAKIT
Rp7.500
RAMUAN HERBAL PENURUN KOLESTROL
Rp4.500
RAMUAN HERBAL PENUMPAS HIPERTENSI
Rp2.750
Menguak Rahasia Ilmu Kedokteran dalam Al-Qur’an
Rp5.700
MENJADI JUARA OLIMPIADE SAINS SD/MI
Rp3.000
BUKU PINTAR FISIKA
Rp3.500
BANK SOAL DAN SOLUSI KIMIA SMA
Rp2.550
ATLAS TUMBUHAN OBAT INDONESIA IV
Rp4.500